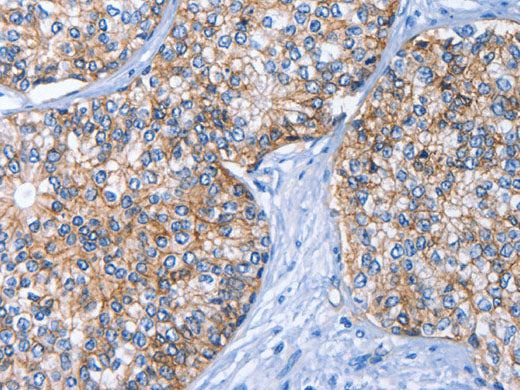
CD239 Polyclonal Antibody

CD239 Polyclonal Antibody
Couldn't load pickup availability

Still have questions? Ask our experts!
CD239 Polyclonal Antibody
| SKU # | E-AB-11053 |
| Reactivity | Human, Mouse |
| Host | Rabbit |
| Applications | WB, IHC |
Product Details
| Isotype | IgG |
| Host | Rabbit |
| Reactivity | Human, Mouse |
| Applications | WB, IHC |
| Clonality | Polyclonal |
| Immunogen | Recombinant protein of human BCAM |
| Abbre | CD239 |
| Synonyms | AU, Antigen identified by monoclonal F8, Auberger B antigen, B CAM cell surface glycoprotein, B cell adhesion molecule, B-CAM cell surface glycoprotein, Ba, Basal cell adhesion molecule (Lu and Au blood groups), Basal cell adhesion molecule (Lutheran blood group) |
| Swissprot | |
| Calculated MW | 67 kDa |
| Cellular Localization | Membrane. |
| Concentration | 0.4 mg/mL |
| Buffer | Phosphate buffered solution, pH 7.4, containing 0.05% stabilizer and 50% glycerol. |
| Purification Method | Affinity purification |
| Research Areas | Cancer, Cardiovascular, Immunology |
| Conjugation | Unconjugated |
| Storage | Store at -20°C Valid for 12 months. Avoid freeze / thaw cycles. |
| Shipping | The product is shipped with ice pack,upon receipt,store it immediately at the temperature recommended. |
Related Reagents
| Applications | Recommended Dilution |
| WB | 1:500-1:2000 |
| IHC | 1:25-1:100 |
Background
This gene encodes Lutheran blood group glycoprotein, a member of the immunoglobulin superfamily and a receptor for the extracellular matrix protein, laminin.The protein contains five extracellular immunoglobulin domains, a single transmembrane domain, and a short C-terminal cytoplasmic tail.This protein may play a role in epithelial cell cancer and in vaso-occlusion of red blood cells in sickle cell disease.Polymorphisms in this gene define some of the antigens in the Lutheran system and also the Auberger system.Inactivating variants of this gene result in the recessive Lutheran null phenotype, Lu(a-b-), of the Lutheran blood group.Two transcript variants encoding different isoforms have been found for this gene.